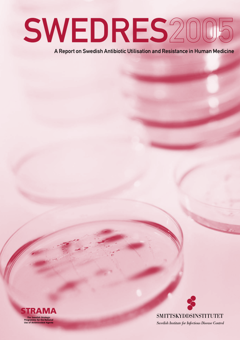

Publications
Here you find all our publications in English listed in alphabetical order.
Publications
-

About your vaccination against diphtheria, tetanus and whooping cough (pertussis)
Published:Updated:This fact sheet is intended for children and youngsters. Diphtheria, tetanus and whooping cough are three serious diseases, but vaccination can protect you.
-

About your vaccination against measles, mumps, and rubella (German measles)
Published:Updated:Useful information for pupils about vaccination against measles, mumps, and rubella within the Swedish vaccination programme.
-

Adverse ecological effects on the individual as a consequence of previous antibiotic exposure – A systematic review
Published:A review and summary of recent studies concerning the adverse ecological effects of antibiotics on the commensal microflora of exposed individuals and the accompanying secondary diseases.
-

Alcohol affects you and those around you
Published:This fact sheet can be handed out to visitors at farm sales of alcohol beverages.
-

Are you in control of your screens?
Published:This leaflet offers tips and advice on screen use and is aimed at teenagers. It also includes a plan to help you find a balance between screen time and other activities.
-

Availability of antibiotics - Reporting of Government commission
Published:The report presents different models for making available both new antibiotics and old antibiotics where national availability is insufficient. The models should also minimise the risk of resistance development while enabling the best possible care for patients with infections caused by multi-resistant bacteria.
-

Availability to antibiotics of particular importance – A Swedish pilot study of an alternative reimbursement model
Published:Updated:In a pilot project, the Public Health Agency of Sweden has investigated whether a model with guaranteed reimbursement to the pharmaceutical company can improve access to particularly important antibiotics in Sweden. An initial evaluation shows that the studied reimbursement model led to increased access to the antibiotic products in our country, earlier than in other comparable European countries.
-

Barriers and motivating factors to MMR vaccination in communities with low coverage in Sweden
Published:The report presents results from a pilot test of Tailoring Immunization Programmes (TIP), a method developed by WHO/Europe to identify barriers and motivating factors to MMR vaccination in communities with low coverage in Sweden.
-

Checklist for high-quality implementation – From news to everyday use
Published:The checklist is a tool that can be used throughout an implementation process, i.e. not something to be read, answered, and abandoned, but something to regularly revisit throughout the process.
-

Covid-19 in schoolchildren – A comparison between Finland and Sweden
Published:In conclusion, closure or not of schools has had little if any impact on the number of laboratory confirmed cases in school aged children in Finland and Sweden. The negative effects of closing schools must be weighed against the positive effects, if any, it might have on the mitigation of the covid-19 pandemic.
-

Ebola and Marburg: Monitoring of returning aid workers – Guidance
Published:The Public Health Agency of Sweden has developed this guidance to support the monitoring of travellers returning to Sweden from countries with active cases of haemorrhagic fever such as Ebola or Marburg.
-

Evaluation of an introduction of vaccination against varicella in the Swedish national vaccination programme for children – Summary of evidence
Published:Updated:The Communicable Diseases Ordinance contains 13 criteria that form the basis of an investigation of vaccination programmes. This knowledge base is a scientific review based on these criteria.
-

Evidence report form
Published:This appendix, a so called Evidence report form, is an annex to the ship sanitation certificate, part of The International Health Regulations (IHR 2005).
-

Folke asks about viruses and bacteria (Conversation cards)
Published:The cards include pictures and text and can be used as they are to read the story Folke, or to talk about individual pictures. The material is intended for children of preschool age.
-

From news to everyday use – the difficult art of implementation
Published:Updated:This report is about implementation, i.e. how new methods can be disseminated and implemented. When new health-promoting methods have been presented, it often takes a long time for them to come into daily use.
-

Good to know about vaccination against tuberculosis
Published:Fact sheet for parents about vaccination against tuberculosis. Tuberculosis is a rare disease in Sweden and the vaccination is only offered to children who have an increased risk of becoming infected.
-

Guidance in the event of a heatwave – For health and social care staff
Published:Updated:This guidance addresses health and social care staff.
-

Guidance in the event of a heatwave – For you, your friends and family
Published:Updated:This guidance addresses at-risk groups and their families.
-

Guidance in the event of a heatwave – Specific guidance for doctors, nurses and other qualified staff
Published:Updated:This guidance addresses qualified staff in health and social care.
-

Health declaration – Vaccination
Published:This form can be used by the regions in connection with vaccination. It can be completed digitally and printed on paper. Other versions Swedish version of this publication Via the link, the fact sheet is also available for download in other languages.
-

Health economic evaluation of a herpes zoster vaccination programme for the elderly in Sweden
Published:This report presents the health economic analyses informing the recommendation of herpes zoster vaccination for adults with increased risk for disease.
-

Health economic evaluation of universal HPV vaccination within the Swedish national vaccination programme for children
Published:This report describes a health economic evaluation that investigates the potential cost-effectiveness of an extension of the national vaccination programme for children against human papilloma virus to also include boys. Today, only girls are offered vaccination within the national vaccination programme.
-

Health economic evaluation of varicella vaccination within the Swedish national vaccination programme for children
Published:This health economic report presents a cost effectiveness analysis of introducing chickenpox vaccination for children in Sweden from a societal and healthcare perspective. It also includes analyses of costs and cost-savings at national and regional levels.
-

How do adolescents view snus?
Published:This factsheet summarise how some adolescents view the use of, exposure to, health aspects of and flavouring of snus.
-

How do you talk about screen use at home? Tips and advice for parents of children aged 13–18
Published:This leaflet offers tips and advice on children’s and adolescents’ screen use. It is aimed at parents and guardians.
-

How do you talk about screens at home?
Published:This poster offers practical tips and advice on children’s screen use.
-

How do you talk about screens at home? Tips and advice on children’s screen use
Published:This leaflet offers practical tips and advice for parents and guardians on children’s screen use. It also includes questions that you can use when talking about screen use in your family.
-

How to wash your hands
Published:The poster in A4 describes what and how you should do to keep your hands clean. Feel free to print it out and put it up in places you think are suitable.
-

How to wear single use face masks
Published:Poster showing how to use a face mask correctly. If used in a correct way face masks can be a compliment to other measures to reduce the spread of infection.
-

Illustrations of health warnings
Published:The publication contains information on how health warnings are regulated as well as illustrations that exemplify how health warnings can be designed and placed on different types of packaging for electronic cigarettes and refill containers, herbal products for smoking, tobacco free nicotine products and tobacco products. Please note that the illustrations are non-binding.
-

Impact on health of climate change in Sweden – A risk and vulnerability analysis
Published:This report highlights how the changing climate affects health in several ways, from heatwaves and spread of infectious diseases to deteriorating water and air quality. The report can provide useful knowledge support for national authorities and county administrative boards affected by the Ordinance on government agencies’ climate adaptation. It may also provide support to other national and international…
-

Infections in preschool
Published:Important information to guardians on when their children should stay at home from preschool in connection with an illness.
-

Influenza in Sweden – Season 2023–2024
Published:This report describes epidemiological and virological surveillance results for the 2023-2024 influenza season in Sweden. Data are also compared to previous influenza seasons.
-

Influenza in Sweden – Season 2024–2025
Published:This report describes the monitoring and surveillance systems for influenza in use during the 2024–2025 winter season and the results of both epidemiological and virological surveillance. Data are also compared to previous influenza seasons. See also the tables and figures section as well as the appendices.
-

Influenza vaccination – Information for pregnant women
Published:The fact sheet on influenza vaccination is a support for those who work with pregnant women. The fact sheet can, for example, be downloaded and distributed at maternity care centers.
-

Information about sales of tobacco-free nicotine products to consumers
Published:The information sheet summarises certain provisions that apply to the sale of tobacco-free nicotine products. It is important that you as a retailer know all the rules that apply to your business.
-

Information about the sale of electronic cigarettes and refill containers to consumers
Published:This information sheet is intended for those who sell or intend to start selling electronic cigarettes and refill containers to consumers (retailers).
-

International Certificate of Vaccination or Prophylaxis
Published:Updated:This leaflet is for sale to medical institutions vaccinating against yellow fever.
-

Interventions to reduce public stigma of mental illness and suicide – are they effective?
Published:Results are based on seven literature reviews where the effects are explored narratively. The report is aimed at officials and stakeholders at regional and local level who are involved in the planning of public health interventions to promote mental health and to prevent mental illness and suicide.
-

Knowledge about the harmful effects of tobacco and nicotine Products
Published:This report is a compilation of existing knowledge about the harmful effects of tobacco and nicotine products in terms of the extent of their use, the health risks and the social costs.
-

Methods and analysis of the long-term follow up of the effectiveness of one whole cell and two acellular pertussis vaccines
Published:Since 1997, the Public Health Agency of Sweden has conducted an Enhanced pertussis surveillance (EPS) of children with pertussis in Sweden. Part of the surveillance includes clinical information and vaccination histories. The methods used in the article are described in more detail in this technical report.
-

National Strategy for Sexual and Reproductive Health and Rights (SRHR) – Good, fair, and equal sexual and reproductive health throughout the population
Published:The Public Health Agency of Sweden has, on behalf of the government, developed a national strategy for sexual and reproductive health and rights. The overall objective of the strategy is to achieve good, fair, and equal sexual and reproductive health in the entire population. The strategy also contains four long-term sub-targets and seven areas of action. Combined, they will contribute to attaining…
-

NCDSim – A Simulation Model for the Future Development of Non-Communicable Diseases
Published:This report documents the NCDSim simulation model, a tool for analysing and projecting future morbidity in cancer and cardiovascular disease and how it is influenced by various modifiable risk factors.
-

Nordic cooperation for a better and more sustainable access to antibiotics
Published:We propose prioritised measures to strengthen access to antibiotics, suitable for collaboration at the Nordic level. A Nordic collaboration could strengthen access to existing antibiotics.
-

Overweight and obesity among school children 11–15-year-old continues to increase
Published:The proportion of school children with overweight or obesity has doubled over the past 30 years according to the results from Health Behaviour in School-aged Children (HBSC), a survey of 11–15-year-olds.
-

Overweight and obesity are common and increase with age in 6–9 year olds
Published:Overweight and obesity among children, 6-9 year old, is becoming more common. In addition, overweight and obesity increase with age and there are geographical differences. Overweight and obesity are common among 6-9 year olds in Sweden. This shows a survey of children's height and weight that was carried out in the academic year 2018/2019. The results also show that overweight and obesity become…
-

Packing samples correctly
Published:The practical guide “Packa provet rätt” is a compilation of the provisions for transport of infectious substances found in the regulations for transport of dangerous goods by road (ADR-S) and by air (IATA-DGR).
-

Patient information – Coughing caused by acute bronchitis
Published:This patient information leaflet about coughing caused by acute bronchitis can be used during a visit to a healthcare centre.
-

Patient information – Impetigo in children
Published:This patient information leaflet about impetigo in children can be used during a visit to a healthcare centre.
-

Patient information – Tonsillitis
Published:This patient information leaflet about tonsillitis can be used during a visit to a healthcare centre.
-

Pertussis surveillance in Sweden
Published:This report is primarily written for health care professionals, particularly those working in maternal and child health care, school health care, primary care, and those working in the counties’ Departments of Communicable Disease Control and Prevention as well as public health officials and authorities in Sweden and elsewhere.
-

Planning for a heatwave in health and social care
Published:This guidance addresses managers and supervisors in health and social care. More guidance, publications and educational materials about health effects of heatwaves (in Swedish).
-

Promote physical activity and limit sedentary behaviour
Published:The recommendations for physical activity and sedentary behaviour apply to all population groups in Sweden, regardless of age, gender, cultural background, socioeconomic status, or disability.
-

Protect your infant against RSV and whooping cough
Published:The fact sheet is primarily aimed at caregivers and can be disseminated through healthcare professionals, particularly in maternal health, child health, paediatric health and primary care.
-

Protect yourself and your baby from infections during pregnancy
Published:Updated:If you are pregnant, vaccination against whooping cough, influenza is recommended for your sake and that of your baby. Here you can read more about why, as well as what these diseases involve.
-

Protection by a third and fourth dose of vaccine against COVID-19 among persons aged 65 years and older – Based on Swedish data from February to August 2022
Published:This report presents an analysis of COVID-19 vaccine effectiveness (VE) after a fourth dose in relation to SARS-CoV-2 infection and severe outcomes due to the omicron variant among persons aged 65 years and older in Sweden.
-

-

Recommendations for children’s and adolescents’ digital media use
Published:The recommendations for children up to 12 years of age are primarily aimed at parents and other adults who meet the children in their everyday life.
-

Report of the Nordic Collaboration on following up on the COVID-19 pandemic
Published:Together with the public health authorities in the Nordic countries including Åland, the Faroe Islands and Greenland, the authority has gathered knowledge and experience from working with the pandemic. The report will be an important basis for continued updates of pandemic plans and for increased cooperation between the Nordic countries.
-

Sexual and reproductive health and rights in Sweden 2017 – Results from the population-based survey SRHR2017
Published:The results show that the sexual health in Sweden is good, 58% of the population report being satisfied with their sex life. Men to a higher extent than women (28% versus 18%) think they do not have sex often enough. More women than men (20% versus 10%) report having felt too tired or stressed to have sex.
-

Sexuality and health among young people in Sweden
Published:The report is mainly intended for employees and decision-makers within county councils, municipalities, civil society organisations as well as relevant authorities and professional associations. The report aims to contribute with knowledge for health promotion and disease prevention work.
-

Sexuality and health among young people living with HIV in Sweden – A study on knowledge, attitudes and behaviour among young people and young adults aged 16-29
Published:This is a report on sexual and reproductive health and rights (SRHR) and STI prevention among young people and young adults (16-29 years) living with HIV in Sweden. The report is based on a survey conducted in 2018. The starting point is the Public Health Agency of Sweden’s work on the national HIV strategy and the follow-up work on SRHR.
-

Smoke-free outdoor environments prevent ill-health
Published:This information sheet describes preventive perspectives of smoke-free environments. It is aimed at you who communicate about smoke-free environments in your professional role e.g. at the county administrative board and municipality or in businesses that are responsible for maintaining a smoke-free environment.
-

Standing together – A national strategy to tackle loneliness
Published:This strategy describes what needs to be done, and at what level of society. We need to work together across government agencies, regions, municipalities, civil society, the business community, academia and the general public.
-

Strengthening access to off-patent antibiotics – Governmental assignment to strengthen access to off-patent antibiotics
Published:In the final report of the government assignment Strengthen access to older antibiotics, three authorities jointly propose various measures to strengthen access to a wide range of older antibiotics in Sweden.
-

Survey of the antibiotic markets in four Nordic countries
Published:A Nordic survey of clinically prioritised antibiotics at risk of insufficient availability shows uncertain access to several medically important antibiotics, especially narrow-spectrum antibiotics and formulations for children. The results indicate noticeable differences in product offerings between the Nordic countries, despite similar medical needs.
-

Swedish work against antibiotic resistance – a One Health approach
Published:This brochure is published by the agencies and organisations included in the Intersectoral Coordinating Mechanism, ICM. The ICM engages governmental agencies and organisations working in human health, animal health, food, environment, research, trade and civil contingency planning and is jointly run by the Public Health Agency of Sweden and the Swedish Board of Agriculture.
-

Swedres 2001
Published:The report shows statistics on antibiotic sales and antibiotic resistance in bacteria from both humans and animals.
-

Swedres 2002
Published:The report shows statistics on antibiotic sales and antibiotic resistance in bacteria from both humans and animals.
-

Swedres 2003
Published:The report shows statistics on antibiotic sales and antibiotic resistance in bacteria from both humans and animals.
-

Swedres 2004
Published:The report shows statistics on antibiotic sales and antibiotic resistance in bacteria from both humans and animals.
-
Swedres 2005
Published:The report shows statistics on antibiotic sales and antibiotic resistance in bacteria from both humans and animals.
-

Swedres 2006
Published:The report shows statistics on antibiotic sales and antibiotic resistance in bacteria from both humans and animals.
-

Swedres 2007
Published:The report shows statistics on antibiotic sales and antibiotic resistance in bacteria from both humans and animals.
-

Swedres 2008
Published:The report shows statistics on antibiotic sales and antibiotic resistance in bacteria from both humans and animals.
-

Swedres 2009
Published:The report shows statistics on antibiotic sales and antibiotic resistance in bacteria from both humans and animals.
-

Swedres 2010
Published:The report shows statistics on antibiotic sales and antibiotic resistance in bacteria from both humans and animals.
-

Swedres 2011
Published:The report shows statistics on antibiotic sales and antibiotic resistance in bacteria from both humans and animals.
-

Swedres-Svarm 2012
Published:Swedres-Svarm 2012 shows statistics on antibiotic sales and antibiotic resistance in bacteria from both humans and animals. The report is a co-production between the Public Health Agency of Sweden the National Veterinary Institute (SVA).
-

Swedres-Svarm 2013
Published:Swedres-Svarm 2013 shows statistics on antibiotic sales and antibiotic resistance in bacteria from both humans and animals. The report is a co-production between the Public Health Agency of Sweden the National Veterinary Institute (SVA).
-

Swedres-Svarm 2014
Published:Swedres-Svarm 2014 shows statistics on antibiotic sales and antibiotic resistance in bacteria from both humans and animals. The report is a co-production between the Public Health Agency of Sweden the National Veterinary Institute (SVA).
-

Swedres-Svarm 2015
Published:Swedres-Svarm 2015 shows statistics on antibiotic sales and antibiotic resistance in bacteria from both humans and animals. The report is a co-production between the Public Health Agency of Sweden the National Veterinary Institute (SVA).
-

Swedres-Svarm 2016
Published:Swedres-Svarm 2016 shows statistics on antibiotic sales and antibiotic resistance in bacteria from both humans and animals. The report is a co-production between the Public Health Agency of Sweden the National Veterinary Institute (SVA).
-

Swedres-Svarm 2017
Published:Swedres-Svarm 2017 shows statistics on antibiotic sales and antibiotic resistance in bacteria from both humans and animals. The report is a co-production between the Public Health Agency of Sweden the National Veterinary Institute (SVA).
-

Swedres-Svarm 2018
Published:Swedres-Svarm 2018 shows statistics on antibiotic sales and antibiotic resistance in bacteria from both humans and animals. The report is a co-production between the Public Health Agency of Sweden the National Veterinary Institute (SVA).
-

Swedres-Svarm 2019
Published:Swedres-Svarm 2019 shows statistics on antibiotic sales and antibiotic resistance in bacteria from both humans and animals. The report is a co-production between the Public Health Agency of Sweden the National Veterinary Institute (SVA).
-

Swedres-Svarm 2020
Published:Swedres-Svarm 2020 shows statistics on antibiotic sales and antibiotic resistance in bacteria from both humans and animals. The report is a co-production between the Public Health Agency of Sweden the National Veterinary Institute (SVA).
-

Swedres-Svarm 2021
Published:Swedres-Svarm 2021 shows statistics on antibiotic sales and antibiotic resistance in bacteria from both humans and animals. The report is a co-production between the Public Health Agency of Sweden the National Veterinary Institute (SVA).
-

Swedres-Svarm 2022
Published:Swedres-Svarm 2022 shows statistics on antibiotic sales and antibiotic resistance in bacteria from both humans and animals. The report is a co-production between the Public Health Agency of Sweden the National Veterinary Institute (SVA).
-

Swedres-Svarm 2023
Published:Swedres-Svarm 2023 shows statistics on antibiotic sales and antibiotic resistance in bacteria from both humans and animals. The report is a co-production between the Public Health Agency of Sweden the National Veterinary Institute (SVA).
-

Swedres-Svarm 2024
Published:Swedres-Svarm 2024 shows statistics on antibiotic sales and antibiotic resistance in bacteria from both humans and animals. The report is a co-production between the Public Health Agency of Sweden the National Veterinary Institute (SVA). Swedres-Svarm 2024 (sva.se) In Swedish Swedres-Svarm rapporten innehåller statistik över antibiotikaförsäljning samt antibiotikaresistens hos…
-

The BSL-4 Laboratory – An important part of the Nordic Public Health Emergency Preparedness
Published:The high-containment laboratory at the Public Health Agency of Sweden in Solna is the only biosafety level 4 (BSL-4) facility in the Nordic countries and one of few in Europe. This brochure describes the facility and the services it provides.
-

The Influenza A(H1N1) 2009 Pandemic in Sweden, 2009–2010
Published:This report summarizes the influenza A(H1N1)2009 pandemic in Sweden between April 24, 2009 and May 23, 2010. The report is based on data from the various surveillance systems used during the pandemic. The systems are presented in some detail to facilitate the reader’s understanding of the quality of the presented data.
-

The prevalence of overweight and obesity among children is high and increases with age
Published:The prevalence of overweight and obesity among children 6–9 years old is high and increases with age. These results were obtained from a survey of a representative sample in Sweden.
-

Towards a good and equitable health – A framework for implementing and monitoring the national public health policy
Published:This report present a short description of a framework for how the reformulated public health strategy will be implemented.
-

Useful information for parents about vaccination against measles, mumps, and rubella
Published:Updated:Useful information for parents about vaccination against measles, mumps, and rubella within the Swedish vaccination programme.
-

Vaccination against mpox – a second update of vaccine recommendations due to increased spread of mpox clade 1
Published:The Public Health Agency of Sweden has updated the recommendations for mpox vaccination due to increased spread of clade 1.
-

What you need to know about HPV
Published:Updated:Information for guardians and students about HPV (human papillomavirus) and vaccination against HPV.
-

What you need to know about rotavirus
Published:Updated:Information for parents about vaccination against rotavirus infection in the Swedish vaccination programme. Rotavirus infection is a highly contagious stomach disease that can be serious for young children. Vaccinating the child is the most effective protection against the infection.
-

What you need to know about vaccination
Published:Updated:Information for parents that describes the illnesses that are part of the vaccination programme for children and gives an overview of the vaccinations given within the child health centre and the student health services.
